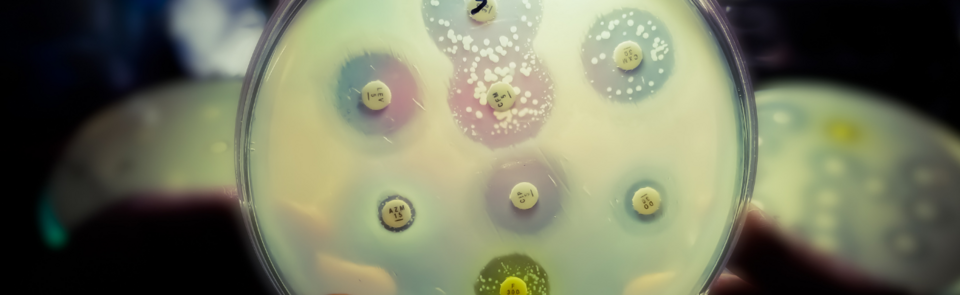

Swab & Send
Join us in the search for new antibiotics.
The secret to saving millions of lives could be behind your sofa, down the back of your fridge, on the bottom of your shoe or even in your pocket… Join us today and help us hunt for the next antibiotic.
Antibiotics are compounds which can stop the growth of, or kill, bacteria that cause disease of humans, animals and plants. They are the cornerstone of modern medicine and also, through agricultural use, secure global food production systems.
However, the bacteria, which are the targets of antibiotics, are evolving resistance at an unprecedented rate and are increasingly becoming less and less effective. This is known as Antimicrobial resistance or AMR, and it is one of the biggest threats to public health globally.
It is estimated that bacterial AMR was directly responsible for 1.27 million global deaths in 2019 and contributed to another 4.95 million deaths.*
Right now, we need more research into the rising levels of resistance, and we urgently need to ensure equitable access to new and existing vaccines, diagnostics, and medicines. We also need new antibiotics. Many people don’t realise that bacteria themselves often produce their own antibiotics to compete in their environment, indeed this is what Alexander Fleming saw on an agar plate when he discovered penicillin in 1928.

Dr Roberts and his brilliant team of researchers are leading the way to finding new antibiotics, and they need your help!
The team is testing tens of thousands of different types of bacteria to see which ones are producing new antibiotics, but with millions of bacteria out there, they need your support to find them.
By donating today, you’ll be helping Dr Roberts and his team work with communities to distribute, collect, and analyse “swabs” that are vital to finding new antibiotics. These swabs, taken by the public, might contain microbes that live in the back of a fridge, gather on a phone, or linger on a light switch. If you choose to give £30 or more, we’ll send you your very own pack of swabs so you can help the search by swabbing and sending them back to be analysed.
Donate today!

If you choose to give £30 or more, we’ll send you your very own pack of swabs so you can help the search by swabing and sending them back to be analysed… Who knows, the answer to a new antibiotic could literally be on your doorstep.
Help us spread the word. Please like and share the Facebook page and talk about antimicrobial resistance and antibiotics with your family and friends.
